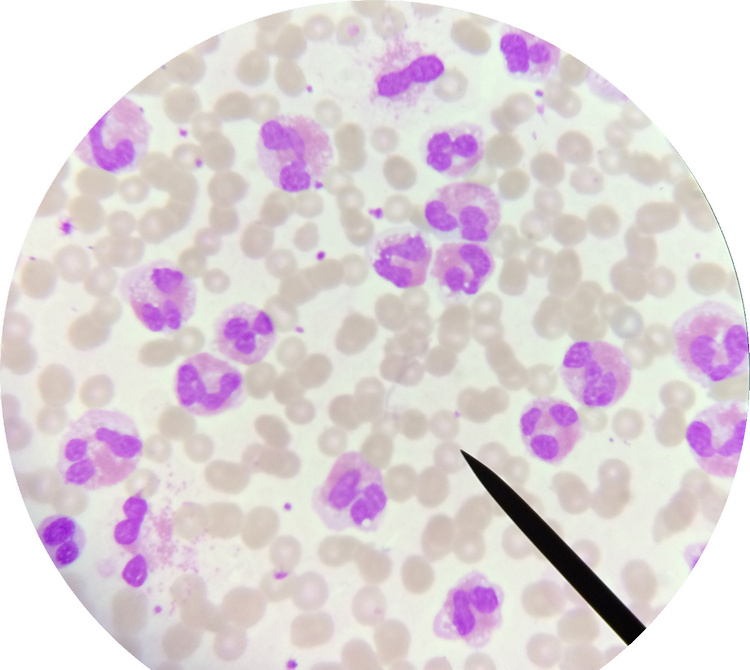

Você já ouviu falar em hipereosinofilia?
Antes de continuar a leitura do texto, quero te convidar para conhecer meus cursos:
- Hematologia básica clique aqui
- Anemias clique aqui
- Onco-hematologia clique aqui
- Interpretando o hemograma clique aqui
- Curso de Hematologia (10% off) clique aqui
- Preparatório de Análises Clínicas para Residência e Concurso clique aqui
Continue agora com a sua leitura do texto. Espero que goste.
Um ponto positivo de estar fazendo uma residência é a oportunidade de ver coisas que provavelmente não veria em outros lugares. Um exemplo disso é um caso intrigante que recentemente chegou ao hospital.
Paciente foi encaminhado pelo posto de saúde devido ao seu hemograma e dor abdominal. Quando passamos a amostra num dos aparelhos do laboratório o resultado não saiu completo, então passamos em outro aparelho cuja metodologia é a citometria de fluxo.
Como resultado obtivemos a contagem global com mais de 200.000 leucócitos/mm3 de sangue. Desses, mais de 90% foram classificados como neutrófilos, apesar de o gráfico ser inconclusivo (FSC x SSC).
Nossa surpresa foi ao analisar a distensão sanguínea. Na verdade não eram neutrófilos e sim eosinófilos. Isso mesmo! Mais de 90% de eosinófilos.
Hipótese diagnóstica: ainda está sendo investigado a possível causa dessa hipereosinofilia, mas suspeita-se de Síndrome Hipereosinofílica ou Leucemia Eosinofílica Crônica. Os resultados dos testes citogenéticos e moleculares ainda não chegaram.
Características das células: no sangue periférico muitos eosinófilos tinham o núcleo segmentado, de três a quatro segmentos; outros eram bastões; grânulos esparsos, geralmente se acumulando em um único lado da célula, deixando áreas do citoplasma livres. Alguns com vacuolização no citoplasma. No mielograma pode-se ver toda a linhagem de maturação do eosinófilo, em grande quantidade, e algumas células com grânulos azurófilos.
Confira algumas fotos que tirei: